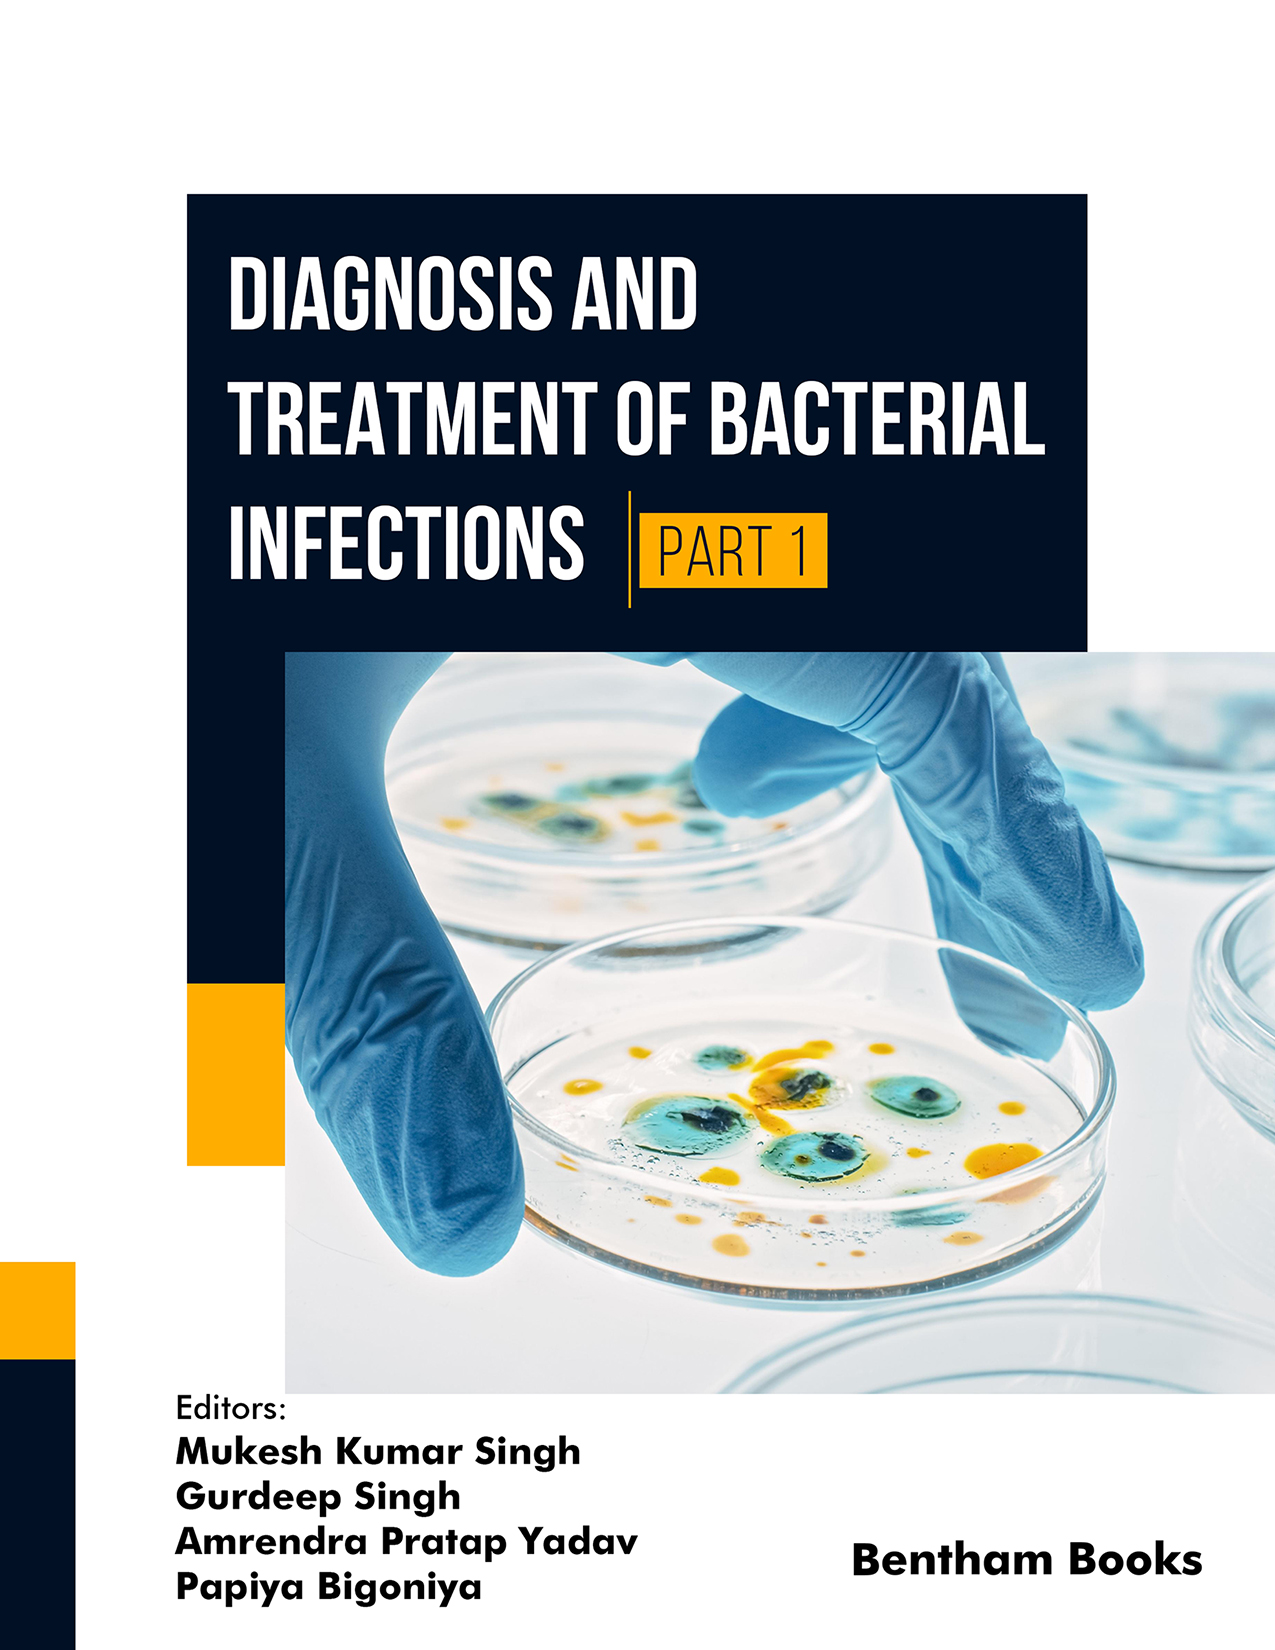
Diagnosis and Treatment of Bacterial Infections (Part 1)

Introduction
Diagnosis and Treatment of Bacterial Infections offers a comprehensive and forward-looking review of bacterial infections, emphasising antimicrobial resistance (AMR) and innovative therapeutic strategies. Bridging microbiology, pharmacology, and clinical science, the book explores bacterial diseases from historical insights to modern molecular understanding, addressing the global challenges posed by resistant pathogens and complex infections. Topics include epidemiology, pathophysiology, limitations of traditional therapies, biofilm-related resistance, and emerging drug delivery methods, providing a holistic perspective for both research and clinical application.
Key Features
- - In-depth coverage of bacterial infections with historical and molecular perspectives.
- - Focus on antimicrobial resistance and biofilm-associated challenges.
- - Discussion of advanced treatment methods and drug delivery technologies.
- - Integrated approach linking basic science, applied therapeutics, and clinical practice.
Target Readership:
Students, researchers, academics and other professionals in microbiology, pharmaceutics, pharmaceutical sciences, and biomedical sciences.